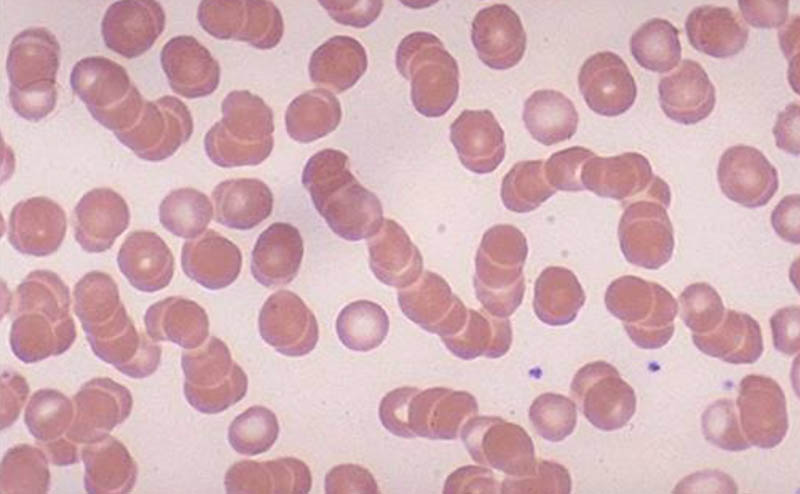

Hyperviscosity Syndrome
Ryan Alcantara, MD - PGY-4
Resident Physician, University of Washington, Department of Emergency Medicine
Rob Klemisch, MD
Editing/assistance
Hyperviscosity syndrome (HVS) is a condition seen in several hematologic disorders characterized by increased blood viscosity leading to impaired microvascular flow and tissue hypoperfusion. The most common cause of HVS is hyperparaproteinemia from plasma cell dyscrasias, usually Waldenström macroglobulinemia (WM). Symptomatic hyperviscosity can also occur due to hyperleukocytosis in leukostasis, a specific type of HVS related to elevated white blood cell counts with distinct clinical implications. Other causes of HVS exist, including those related to other hematologic disorders, but this article will primarily focus on Waldenström macroglobulinemia.
Critical hyperviscosity is a hematologic/oncologic emergency that requires prompt recognition and treatment to prevent life-threatening complications. Most patients do well with treatment, but without timely intervention, hyperviscosity can rapidly lead to irreversible end-organ dysfunction and death. Early intervention can significantly decrease the risk of long-term sequelae. Intensivists and emergency physicians must be able to recognize this disease process in at-risk patients, coordinate with hematology/oncology for definitive management, and aggressively manage complications.
Pathogenesis
Hyperviscosity syndrome occurs in up to 30% of patients with Waldenström macroglobulinemia, a rare type of non-Hodgkin lymphoma characterized by the overproduction of monoclonal IgM antibodies, and less commonly, in 2-6% of patients with multiple myeloma. The elevated levels of monoclonal immunoglobulins, particularly IgM, dramatically increase the viscosity of the blood. This leads to sluggish blood flow, endothelial cell damage, and impaired microvascular perfusion, resulting in tissue hypoxia and bleeding. In addition to the impact on blood viscosity, the increased circulating proteins can affect platelet aggregation and worsen bleeding complications.
The large size and pentameric structure of IgM antibodies make them especially prone to increasing blood viscosity. In multiple myeloma, hyperviscosity is more commonly associated with high levels of IgA paraproteins. It can also be seen following initiation of anti-CD-20 therapy (e.g., Rituximab) due to transient increases in immunoglobulin levels following treatment.
The severity of clinical symptoms is directly related to the increased levels of serum viscosity. As the individual patient's serum viscosity rises, they will experience progressively more severe symptoms. The level of viscosity at which symptoms can initially present is variable from person to person, but for a given patient, symptoms will typically manifest at about the same level of viscosity over time.
 Image Source: https://scioly.org/wiki/images/5/5e/IGTypes.jpg
Image Source: https://scioly.org/wiki/images/5/5e/IGTypes.jpg
Clinical Presentation
Symptoms of hyperviscosity syndrome can involve nearly any organ system and are related to tissue ischemia from obstruction and/or bleeding. However, mucosal bleeding, visual disturbances, and neurological abnormalities are the most common.

- Mucosal bleeding is the most common manifestation, including epistaxis, gingival bleeding, and gastrointestinal bleeding.
Recurrent presentations for epistaxis, particularly when bilateral and in a patient with an underlying plasma cell dyscrasia or other compatible symptoms, should raise suspicion for this diagnosis. - Neurologic manifestations are often the most prominent feature of HVS and occur due to decreased cerebral blood flow. Symptoms vary in severity and can include headaches, vertigo, tinnitus, mental status changes, seizures, and stroke.
- Visual manifestations arise secondary to microvascular changes in the retinal vessels and, when present, are highly suggestive of symptomatic hyperviscosity. In severe cases, this can result in bilateral central retinal vein occlusion and permanent vision loss.
Fundoscopic findings include retinal hemorrhages, exudates, microaneurysms, and papilledema progressing to frank central retinal vein occlusion. The classic "sausage link" appearance of dilated, segmented, and tortuous retinal veins is considered a pathognomonic finding.
The presence of these retinal changes that are not attributable to an alternative etiology should immediately trigger oncologic consultation and therapeutic intervention.
 Retinal venous engorgement, retinal hemorrhages, and venous tortuosity in a patient with central retinal vein occlusion
Retinal venous engorgement, retinal hemorrhages, and venous tortuosity in a patient with central retinal vein occlusion
Image Source Link
Diagnosis
Diagnosis of HVS relies on a combination of clinical presentation, serum viscosity measurement, and quantitative immunoglobulin testing.
Serum viscosity measurement is the key diagnostic test, with symptoms often beginning when viscosity exceeds 4 centipoise (cP), compared to a normal value of 1.5 cP. Most patients are symptomatic when serum viscosity is greater than 6 cP. However, the correlation between serum viscosity and clinical manifestations is not precise, as the symptomatic threshold can vary between patients.
Many laboratories do not have the capability to directly measure serum viscosity, and the results can take time to obtain. In these situations, supportive evidence can come from other laboratory findings:
Useful clues that support a diagnosis of HVS include:
- Protein gap = Total protein - Serum albumin
The risk of HVS is directly proportional to the magnitude of the paraprotein elevation. It is uncommon to have HVS with a paraprotein level below 4 g/dL, so a protein gap less than 4 g/dL argues against HVS, though it does not exclude the diagnosis. - Rouleaux formation
Rouleaux formation on peripheral blood smear can be used as a surrogate for serum viscosity measurements, as its presence is highly suggestive of serum stasis.
- Fundoscopic exam
If available, ophthalmologist consultation can be obtained to evaluate for the characteristic fundoscopic findings, the presence of which correlates with the symptomatic threshold for HVS. In the proper clinical setting, this can secure the diagnosis and prompt the initiation of treatment.
Given that HVS is an oncologic emergency requiring prompt treatment, a low threshold should be maintained for initiating therapy in any patient with an underlying plasma cell dyscrasia who presents with bleeding, neurologic or visual symptoms, or evidence of unexplained organ failure. Treatment should not be delayed for serum viscosity testing.
Management
The mainstays of treatment include therapeutic plasma exchange, aggressive supportive care, and cytoreductive chemotherapy. The patient should be immediately hospitalized and transferred to an oncology center with expertise in managing complex oncologic emergencies, and oncology should be immediately consulted to coordinate care. Dehydration will worsen HVS, so if there is any suspicion, promptly administer crystalloid.
Plasmapheresis is the mainstay of acute management for hyperviscosity syndrome. Plasmapheresis can quickly lower the serum viscosity and alleviate the clinical manifestations of hyperviscosity. This is typically done gradually, removing approximately 25% of the patient's plasma volume per session.
In resource-limited settings, a temporizing measure that can be considered is judicious phlebotomy with concurrent crystalloid and/or blood product replacement. However, this should only be attempted in severe scenarios and performed with caution, as it can potentially cause harm.
Supportive care is an essential component of managing HVS. This includes judicious hydration, as above. Avoiding red blood cell transfusions and diuretics, which can further increase viscosity, and managing any potential complications such as bleeding or thrombosis are also important.
Plasmapheresis does not treat the underlying malignancy, so cytoreductive chemotherapy is often started concurrently to prevent recurrence of the hyperviscosity. Chemotherapeutic agents that lead to rapid reduction of the viscosity include Bortezomib, Ibrutinib, and Carfilzomib, but the most appropriate chemotherapy regimen will be determined by hematology/oncology. Rituximab is often avoided, as it can increase serum levels of IgM and worsen hyperviscosity.
Outcomes
Without prompt treatment, hyperviscosity syndrome has a very high mortality rate, often exceeding 50%.
However, with rapid initiation of plasmapheresis and cytoreductive therapy, the mortality rate can be reduced to 10-20%.
Outside of episodes of hyperviscosity, Waldenström macroglobulinemia is generally an indolent, well-tolerated disease, with a median survival of over 10 years with modern therapy. Many patients will die of causes other than their underlying WM, especially those diagnosed at an older age. With appropriate treatment, the prognosis for patients with Waldenström macroglobulinemia-associated hyperviscosity is generally favorable. Prompt recognition and management of hyperviscosity is critical, as it can significantly decrease the risk of long-term sequelae and improve outcomes for these critically ill patients.
Take Home Points
- Hyperviscosity syndrome is a medical emergency that requires prompt identification and treatment.
- The classic triad of hyperviscosity syndrome is mucosal/skin bleeding, neurologic deficits, and visual disturbances.
- Although high serum viscosity leads to hyperviscosity syndrome, the presence of symptoms is more important than the absolute viscosity value in making the diagnosis and initiating management.
- With classic signs or symptoms, especially in the presence of a predisposing condition, oncologic consultation and therapeutic intervention may need to be done prior to obtaining the results of serum viscosity.
References
- Ballestri M, Ferrari F, Magistroni R, et al. Plasma exchange in acute and chronic hyperviscosity syndrome: A rheological approach and guidelines study. Ann Ist Super Sanita, 2007;43(2):171–5.
- Gertz MA. Acute hyperviscosity: Syndromes and management. Blood. 2018;132(13):1379–85. https://doi.org/10.1182/blood-2018-06-846816
- Mehta J, Singhal S. Hyperviscosity syndrome in plasma cell dyscrasias. Semin Thromb Hemost. 2003;29(5):467–71. https://doi.org/10.1055/s-2003-44554
- Perez Rogers A, Estes M. Hyperviscosity Syndrome. 2024. In StatPearls Publishing. http://www.ncbi.nlm.nih.gov/books/NBK518963/
- Schwartz J, Winters JL, Padmanabhan A, et al. Guidelines on the use of therapeutic apheresis in clinical practice-evidence-based approach from the Writing Committee of the American Society for Apheresis: The sixth special issue. J Clin Apher. 2013;28(3):145–284. https://doi.org/10.1002/jca.21276
- Stone MJ, Bogen SA. Evidence-based focused review of management of hyperviscosity syndrome. Blood. 2012:119(10):2205–8. https://doi.org/10.1182/blood-2011-04-347690
- Papadakis MA, McPhee SJ, Rabow MW, et al. Current Medical Diagnosis & Treatment 2024. New York; McGraw-Hill; 2024.




